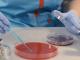
Ескулаб

Описание
Медична лабораторія Ескулаб пропонує величезний вибір аналізів, які можна здати як комплексним пакетом, так і окремо за порадою вашого лікаря. Ви можете легко зайти до них, щоб просто перевірити стан здоров’я або здати конкретне дослідження без зайвих черг. Лабораторія максимально спростила сервіс, тому ви можете записатися на візит онлайн та швидко оплатити послуги банківською карткою прямо на місці.
У Ескулаб працюють турботливі фахівці, які проводять урогенітальний забір та вміють знайти підхід навіть до немовлят віком до одного року. Спеціалісти лабораторії розуміють, як важливо забезпечити дитині спокій, тому роблять забір аналізів максимально лагідно та професійно. Ваші результати будуть готові вчасно, а точність досліджень допоможе вам бути впевненими у своєму самопочутті.